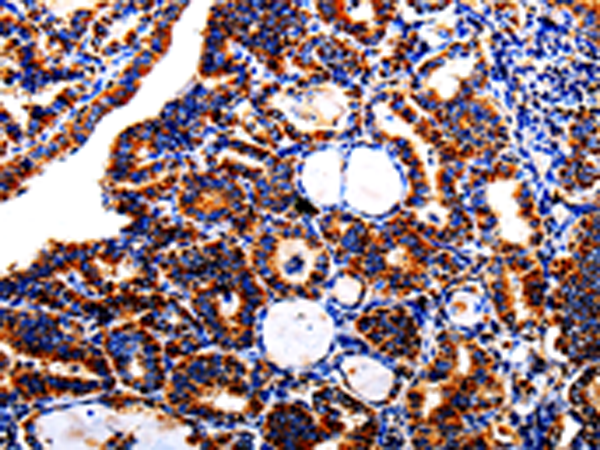
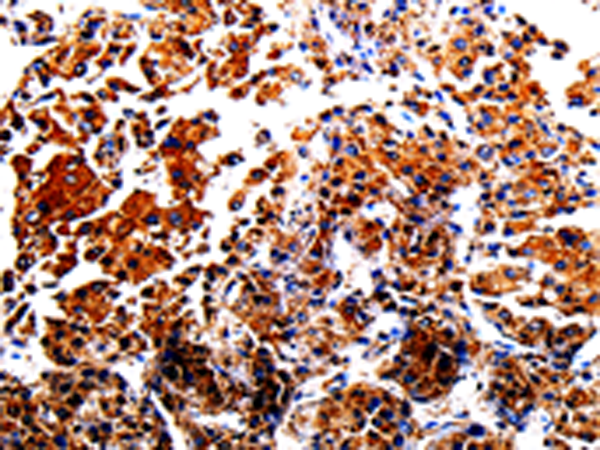
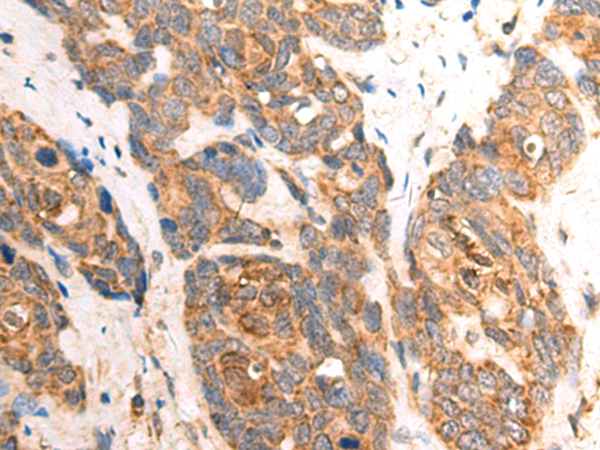

-
分类: 科研抗体货号: P06989别名: CPP32; SCA-1; CPP32B应用: WB,IHC反应种属: Human, Mouse, Rat
-
分类: 科研抗体货号: P06971别名: FETA, HPAFP应用: WB,IHC反应种属: Human
-
分类: 科研抗体货号: P06951别名: MEH; EPHX; EPOX; HYL1应用: IHC反应种属: Human, Mouse, Rat
-
分类: 科研抗体货号: P06988别名: BCL2L4应用: WB,IHC反应种属: Human, Mouse, Rat
-
分类: 科研抗体货号: P06970别名: ADDA应用: IHC反应种属: Human, Mouse, Rat
-
分类: 科研抗体货号: P06950别名: ATLD2应用: WB,IHC反应种属: Human, Mouse, Rat
-
分类: 科研抗体货号: P06987别名: BBC2; BCL2L8应用: IHC反应种属: Human
-
分类: 科研抗体货号: P06969别名: GCS1L; CENTA1; p42IP4应用: WB,IHC反应种属: Human, Mouse
-
分类: 科研抗体货号: P06949别名: 1A; GDIL; MRX41; MRX48; OPHN2; XAP-4; RABGD1A; RABGDIA应用: WB,IHC反应种属: Human, Mouse, Rat
-
分类: 科研抗体货号: P06986别名:应用: IHC反应种属: Human

鄂公网安备42018502007531号
鄂公网安备42018502007531号

